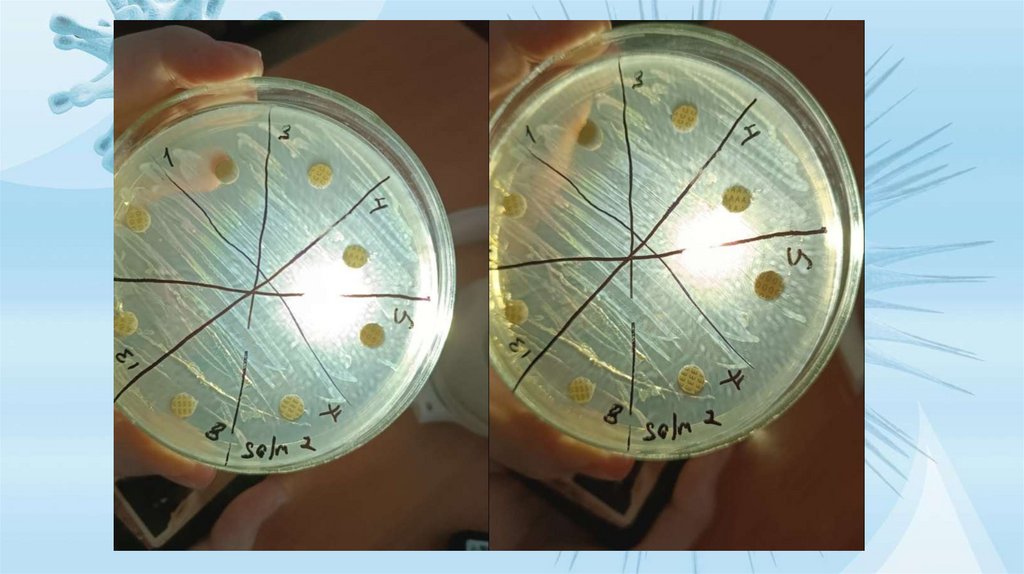

Похожие презентации:
Отчёт по учебной практике (19.05-06.06). Кафедра: «Микробиология, вирусология и иммунология»
1.
Кафедра: «Микробиология, вирусология и иммунология»6В09104 – «Ветеринарная медицина»
Выполнили: студенты 2-го курса ВМ 23-07
(вторая подгруппа)
Проверили:
Жылқайдар А.Ж
Бияшев Б.К
Киркимбаева Ж.С
2. Содержание: 1.Титульный лист. 2.План. 3.Состав подгруппы. 4.Отчет по практике. 5.Заключение, вывод.
3.
1. Анна Бруж2. Лейла Акпарова
3. Данияр Казымов
4. Елизавета Бугаенко
5. Ева Яковенко
6. Айжан Ардаккызы
7. Аружан Куранышева
8. Валерия Алексеева
9. Ляззат Джанашева
10.Виталий Щенников
4. Первый день.19.05.
Изучили: методыстерилизации
микробиологической
посуды, ознакомились с
типами посуды (чашки
Петри, колбы). Приготовили,
помыли посуду для
микробиологических
исследований, . приготовили
ватные пробки для
пробирок, стерильных
ватных палочек для взятия
проб.
5. Второй день 20.05
Изучили: методы стерилизации,требования к питательным средам,
состав и рецептуру питательных
сред.
Приготовление мясо-пептонного
бульона (МПБ).
4 грамма готовой сухой смеси,
смешали с 250мл
дистиллированной воды, нагрев
раствор до растворения порошка.
Цвет готового раствора был
бледно-коричневого (не крепкий
чай) с pH 7.2.
6. Третий день 21.05.
Исследуемая мышь №2. Вскрытие.Изучали патогенные и вирулентные
свойства микроорганизмов:
У мыши было посиневшее брюшко,
чистые лапки и нос, следы поноса.
После вскрытия мы наблюдали
увеличенную печень с очагами
кровоизлияний, черную селезенку,
цвет внутренней серозной оболочки
брюшной полости красно-розовый,
так же наблюдался прозрачный
экссудат, вздутый желудок. Легкие и
почки были без изменений, в сердце
наблюдалось кровоизлияние
Мы сделали посев на МПБ и МПА,
из печени.
7.
Сделали мазок отпечатокследующих органов:
Селезенка, сердце, легкое и печень
Окрашивали их простым методом
и по Грамму.
• Сердце: мазок был сделан не
правильно, ничего не увидели.
• Легкое: видны артефакты
(кристаллы краски) и
палочковидные бактерии.
• Селезенка: наблюдались
артефакты и палочковидны Гбактерии
• Легкое: наблюдался вибрион в
одном количестве
• Печень: виднелись артефакты и
палочковидные Г- бактерии
8. День четвертый 22.05.
Делали разведениена чистую культуру в
среды агар, Висмутсульфатный агар и
Эндо
Первый метод:
методом
Дригальского в агаре
Второй метод:
Поверхностный
посев в Эндо и ВсА.
9. Пятый день 23.05.
Изучили: морфологические икультуральные свойства
чистой культуры, исследовали
биохимические или
ферментативные свйойства
микроорганизмов. Выполнили
посев на среду Гисса. В среду
Гисса входят следующие
среды: Глюкоза, сахароза,
лактоза, мальтоза, салицин и
образование газов индол,
сероводород и аммиак.
10. Шестой день. 26.05
Изучали патогенныевирулентные свойства
микроорганизмов путем
биологической пробы.
Использовали метод
заражения:
внутрибрюшинное
введение, ввели в
нижнюю 3/1 часть
живота, немного в
сторону белой линии 0,1
мл.
11. Седьмой день 27.05
Мы вскрывали труп погибшей мыши которуюзаразили в шестой день.
Описание мыши:
Сине-зеленое брюхо, лапки и нос розоватого
цвета, следы поноса.
При вскрытии:
Метеоризм – большое количество газов в
кишках, изменение гнойного характера в слепой
кишке.
Печень нормального размера с зеленоватым
налетом, вздутый желудок, селезенка темнокрасного цвета, не увеличена. Серозная
оболочка брюшной полости зеленоватого цвета,
наблюдался экссудат.
В сердце наблюдается кровоизлияние, легкие
бледно-розового цвета.
12.
ПосевМПБ и
МПА из
печени
Мазкиотпечатки
из органов
печени,
почки,
селезенка
и легкие.
13. Восьмой день 28.05.
Изучили принципыпостановки реакции
агглютинации,
применение реакции
при идентификации
возбудителя.
Реакция
агглютинации слабоположительная.
14. Девятый день 29.05
ПризнакОписание
Признак
Описание
Форма
S
Консистенция
Желеобразная
Цвет
Черное
Край
Округленное
Профиль
Выпуклое
Поверхность
Глянцевая
Форма
Палочковидное с округленными краями
Расположение
Единичное
Наличие спор
-
Наличие капсул
+
Окраска по грамму
Г-
Глюкоз
а
Сахаро
за
Лактоз Мальт
а
оза
Салиц
ин
Образование газа
Индол
Сероводо
род
Аммиак
-
-
-
-
+
+
-
-
Идентификация
микроорганизмов
по биологическим
свойствам, анализ
морфологических,
культуральных и
биохимических
характеристик
бактерий.
15. Десятый день 30.05.
Названиеантибиотиков
Резистентность
Тетрациклин
13мм
Хлорамфеникол
11мм
Ампициллин
9мм
Окситетрациклин
10мм
Эритромицин
13мм
Не резистентность
Стрептомицин
20мм
Оксациллин
17мм
Олеандомицин
9мм
Резистентность 9мм
Средняя чувствительность 10-15мм
Чувствительность 15-20мм
16.
17. Заключение, выводы:
За время практики мы обучились подготовкелабораторного оборудования, приготовление
питательных сред. Стали лучше понимать
этапы работы в микробиологической
лаборатории.
Провели самостоятельное изучение и
определение микроорганизмов, а так же
способы изучения морфологических,
биохимических, антигенных свойств
полученного нами организма – Salmonella.
Провели тест на резистентность и узнали что у
нашего микроорганизма устойчивость к
хлорамфеникол, ампициллин,
окситетрациклин, олеандомицин.
Микроорганизм средне-чувствителен к
тетрациклину и эритромицину, и он
чувствителен к стрептомицину и оксациллину.

Биология
Биология








